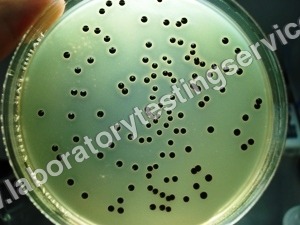
Shelf Life Study

- Tradeindia
- Sigma Test & Research Centre
Delhi, Delhi, India|Accepts only Domestic inquiries
Sigma Test & Research Centre
Quality manager
Mr. Rahul Gupta
Address
BA-15, Phase -2, Mangolpuri Indl. Area, Delhi, Delhi, 110034, India
About Sigma Test & Research Centre
Business Type
Service Provider
Employee Count
20
Establishment
2009
Payment Mode
Top Products & Services
FAQs : Sigma Test & Research Centre
View More Products From This Seller
Popular Products in Cities
Refractory Materials in Morbi|
Hardness Testing Machine in Delhi|
Abrasion Testing Machine in Delhi|
Product Testing Services in Delhi|
Drinking Water Test Kit in Delhi|
Salt Spray Test Chamber in Delhi|
Thermocouple Calibrator in Delhi|
Ultrasonic Testing Equipment in Delhi|
Ultrasonic Testing Machine in Delhi|
Transformer Oil Testing Machine in Delhi|
Water Testing Equipment in Delhi|
Aggregate Crushing Value Apparatus in Delhi|
Automated Test Equipment in Delhi|
Seller Details
Quality manager
Mr. Rahul Gupta
Address
BA-15, Phase -2, Mangolpuri Indl. Area, Delhi, Delhi, 110034, India
Service Providers In DelhiPopular Products
Human HairForklift TrucksServo Voltage StabilizerBasmati RiceBackhoe LoaderCarry Bag Making MachineDrum LifterElectric StackerScissor LiftsIndustrial Vibrating ScreenRotameterFlowmeterRotary Air CompressorIndustrial Eto SterilizerRice Packaging MachinesShredding MachineHammer MillAutomatic Labelling MachineDiesel ForkliftAerial Work PlatformStorage Rack SystemEpoxy ResinMild Steel BarStainless Steel SheetsStainless Steel StripsBag Filling MachinesAsphalt PlantsSlat ConveyorOintment PlantPlanetary MixersLadies KurtisLed LightsCctv CameraBall ValveAnti Cancer MedicineAir CompressorIncense SticksSolar LightsGoods LiftsVitrified TilesStainless Steel CoilsPvc PipesPvc Pipe FittingsUpvc PipesUpvc Ball ValvePipe Elbows